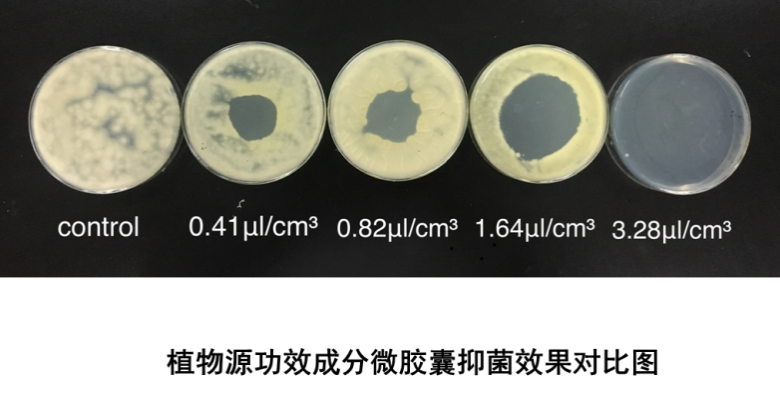

技术名称:功效因子装载技术
技术简介:
团队研究领域主要集中在抗氧化、抗菌与储能活性物质的纳微封装等技术。包括:
1. 天然精油/香精香料的多孔缓释微胶囊技术;
2. 高效护肤因子的密闭微胶囊技术;
3. 热感微胶囊技术;
4. 凉感微胶囊技术;
5. 纳米级抗氧化技术;
6. 天然源物质制备等。
技术优势:微胶囊技术保护功效成分。
1. 保护功能材料的作用
2. 隔离不相容组分
3. 控制释放
4. 屏蔽作用
5. 改变芯材性质
6. 改变物质功能
7. 美化产品
技术成效:
针对功效因子的封装技术,目前已经授权10余项发明专利。相关科研成果,共计发表50余篇论文,其中20余篇SCI文章,他引率超过300次,最高影响因子>5。承担国家、省部级项目10余项。与10余家企业开展实际应用研究,部分为国内客户提供的中试样品,全部通过日本、美国等国家相关部门的检测指标。部分专利情况如下:
1. 一种真丝织物天然精油芳香整理剂及其制备方法 201310410614.2
2. 一种双层芳香相变微胶囊织物整理液及制备方法和应用 201310410066.3
3. 一种恒温双层天然精油抑菌剂及其制备方法 201410176822.5
4. 一种用于清凉爽肤功能面料的微胶囊整理剂及制备方法 201611013286.2
5. 一种高稳定性的美藤果油水润Q弹珠的制备方法 201710989450.1
6. 一种具有热敷功能的无水微波加热储能微胶囊及制备方法 201610613250.1
7. 一种以无机材料为壁材的相变储能微胶囊及其制备方法 201610908541.3
8. 一种含有薰衣草精油微胶囊的安神晚霜 201611115539.7
9. 一种含有美藤果油的纳米精华液及其制备方法 201710063214.7
10. 一种含有无患子皂苷的洗手液及其制备方法 201710301288.X
11. 一种含有美藤果油的纳米体系导入液及其制备方法 201710300720.3
12. 一种装载水杨酸的复合壁材微胶囊及其制备方法 201810022817.7
13. 一种包含水杨酸微胶囊的祛痘美容手工皂及其制备方法 201810249217.4
14. 一种水包油型美藤果油微乳液的制备方法 201810523091.5
15. 一种用于3D打印的芳香微胶囊及其制备方法 201810621043.X
16. 一种包含水杨酸微胶囊的洗面奶及其制备方法 201811130943.0
17. 一种含有美藤果油微胶囊的柔肤水及其制备方法 201910423998.9
18. 一种含有鞣花酸的水凝胶微球及其制备方法 201910707064.8
19. 一种壬二酸超分子的制备方法 201910922949.X

技术应用:
1. 化妆品功能材料
2. 食品抗菌抗氧化活性原料
3. 建材、冷链等行业保温材料


联系人:
宋晓秋 18019419873